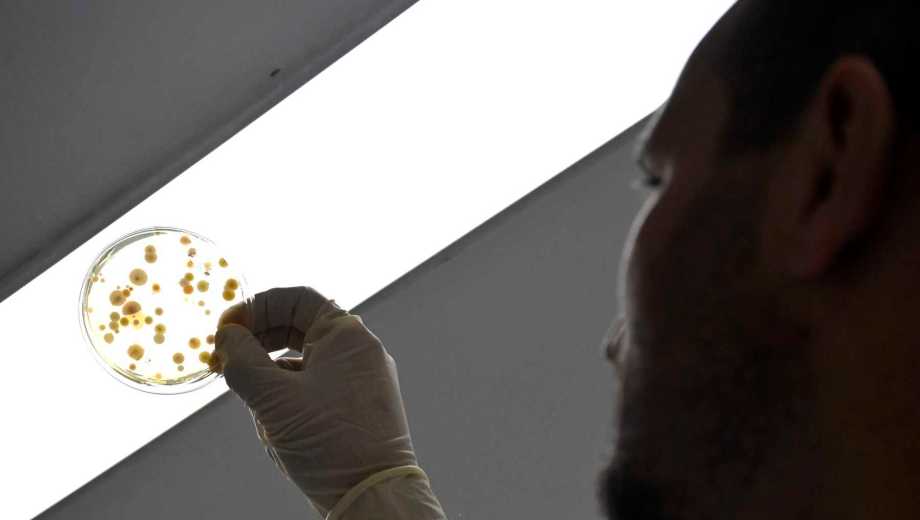

El laboratorio de Río Negro proveerá medicamentos al Ipross
La fabricación de medicamentos en el Profarse se focalizará ahora a la obra social provincial, además de la red de hospitales públicos. Crece la producción.
El gobierno provincial está enfocado en cumplir -finalmente- con el plan de que su laboratorio Profarse provea de sus medicamentos a los afiliados a la obra social provincial, Ipross.
Hasta ahora, la producción farmacéutica se destina a los hospitales rionegrinos, como también, hay operaciones con Nación y otras provincias.
Nunca existieron avances en la provisión a la obra social provincial, con 180 mil afiliados y que destina actualmente más del 50% de sus recursos a medicamentos. El inconveniente recae en la logística de distribución en toda la provincia y la presidenta del Ipross, Marcela Ávila, resolvería esa situación con una licitación para contratar ese servicio.
En consecuencia, Profarse planificó una fuerte suba de su producción para este año con el objetivo de más entrega en los hospitales y la puesta en marcha con el Ipross. En esa línea, el gobernador Alberto Weretilneck repitió esa intención en su equipo y, además, Hacienda inyectó últimamente recursos adicionales al laboratorio.

Según el número original, Profarse tiene un presupuesto de 1.100 millones de pesos para el 2024 aunque, luego registró correcciones “por dificultades financieras experimentadas en el último ejercicio y que afectan varias esferas de la actividad de la empresa”, esencialmente en los haberes del personal, que totalizan 32 agentes, entre técnicos, operarios y directivos, y que están enmarcados en el convenio colectivo del personal de la Sanidad (ATSA).
En cifras
- 6.000.000
- Unidades fue la producción del 2023 que Profarse informó y, 4 millones de sobres de complementos nutricionales.
Para este año, el informe presupuestario plantea mayor producción ya “no sólo por la cobertura en los hospitales” sino “también diferentes posibilidades abiertas a nivel nacional”. Así, recordó que Profarse firmó en el 2023 un convenio con Nación por el Producto Fierritas, que se trata de un complemento nutricional en polvo, y que “existe un preconvenio para este 2024” donde se aumenta en “un 66,6% la cantidad de sobres” para entregar.
Profarse estimó un alza de un 70% de su producción en relación al 2023, a partir de una cobertura superior de la demanda de hospitales provinciales, “ampliando la nómina de los productos” y el incremento de la provisión de Fierritas. Incluso, en su análisis, estima que “surge adicionalmente la posibilidad certera de contar con el primer producto certificado por ANMAT”, lo cual, “las oportunidades de venta aumentan considerablemente”.

El año pasado, el laboratorio consignó una producción de 6 millones de unidades y 4 millones de Fierritas.
Sus productos se vinculan con la diabetes, la presión arterial, antiinflamatorios, antibióticos, rifampicina (para tubercolosis), diclofenac (artritis), metformina (control de la glucosa en sangre), como también, ibuprofeno, paracetamol y aspirina (los tres para aliviar dolor y bajar la fiebre).
Así, se informó de un superávit de 5,5 millones de pesos en el 2023 y se calcula para el 2024 un resultado positivo superior a los 92 millones de pesos, “representando un 9,80% sobre los recursos totales”.
Las dificultades aparecen con demoras en los cobros y, por eso, Hacienda sale al rescate.
Según el presupuesto, el “financiamiento del laboratorio rionegrino se integra con un 90% por recursos genuinos propios por las ventas a hospitales”, a otras provincias y al “ministerio de Salud de Nación” por los sobres Fierritas. El otro 10% se prevé por subsidios nacionales.
Además, en su planeada expansión, a fines del año pasado, la Legislatura sancionó una ley que permite la toma de créditos para “poder hacer frente a sus obligaciones de manera más ágil”.
Un funcionario del Ipross es el nuevo presidente del Profarse
Una mirada distinta del gobierno provincial hacia su laboratorio estatal se presume, que derivaría en un protagonismo mayor en la provisión de medicamentos al sistema sanitario si finalmente se cumple con las prioridades y acciones expuestas por las autoridades de Río Negro.
En esa dirección parece encuadrarse el nuevo directorio del Profarse, cuya presidencia recayó en Facundo Villagrán, que es secretario general técnico de la obra social rionegrina.

Esta pertenencia al Ipross colaborará -seguramente- con la siempre buscada interrelación, intercambio y asistencia del laboratorio al sistema público de Salud y a la obra social.
Históricamente, la presidencia fue ocupada por el titular de la cartera sanitaria.
La vicepresidenta del directorio es la legisladora de JSRN, Andrea Escudero, quien fue vocal gubernamental del Ipross durante años mientras que la ministra de Salud, Ana Senesi; la presidenta de la obra social, Marcela Ávila y el legislador del bloque PJ-Nuevo Encuentro, Pedro Dantas, se integran como directores titulares. En la gerencia general se mantiene Marne Livigni.

Villagra resaltó la “importancia estratégica del directorio para la implementación de políticas de cuidado de salud” y “pieza en la articulación de ministerio de Salud e Ipross”.
Adelantó que se buscará “llevar a los afiliados los productos” del laboratorio e integrar a “Profarse a la red de prestadores y proveedores” de la obra social estatal.
Para la ministra Senesi, el laboratorio inicia “una nueva etapa” porque “la idea es seguir trabajando para impulsar nuevos proyectos y continuar fortaleciendo el desarrollo de la producción pública rionegrina”, afirmó en una recorrida días atrás.
El gobierno provincial está enfocado en cumplir -finalmente- con el plan de que su laboratorio Profarse provea de sus medicamentos a los afiliados a la obra social provincial, Ipross.
Registrate gratis
Disfrutá de nuestros contenidos y entretenimiento
Suscribite por $1500 ¿Ya estás suscripto? Ingresá ahora